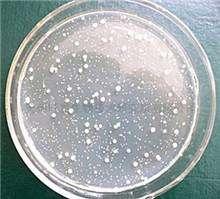
如何养水建立硝化系统,养水启示录硝化系统

大家好,上期我们已经详细讲解了过滤系统,对硝化系统只是浅尝辄止,现在我们就来聊一聊做好硝化系统。众所周知,硝化系统核心就是硝化细菌!
一、硝化细菌是什么?

硝化细菌是一类好氧性细菌,包括亚硝酸菌和硝酸菌,使用形态主要有液态和干粉。生活在有氧的水中或砂层中,在养鱼水系统氮循环水质净化过程中扮演着很重要的角色。
二、认识误区

不少鱼友对硝化细菌的认识产生了一定的误解,有的人认为硝化细菌能够分解粪便,有的认为可以净化水质,中和水中的悬浮物,这些认识是不准确的,或者可以说是错误的。
明确4点:硝化菌并不能分解鱼排泄物,硝化菌并不能改善水质白浊的问题,硝化菌并不能分解水中的硫化氢(H2S),硝化菌无法将氨(NH3)直接氧化为硝酸盐(NO3)。
三、硝化细菌工作原理

硝化细菌的作用是净化氨。
硝化细菌是如何工作呢?硝化菌要先将氨(NH3)氧化为亚硝酸盐,然后再将为亚硝酸盐氧化为硝酸盐,硝酸盐再被植物吸收或者换水被稀释。
硝化细菌的生存环境,生化棉和细菌屋等生化滤材是专门用于培养硝化细菌的,具有很大的表面积。硝化细菌的生长需要氧气,二氧化碳不但对硝化菌无害,而且硝化菌需要靠二氧化碳来繁殖和生存,硝化细菌的生长不需要阳光。
硝化细菌是无所不在的,但是硝化细菌在鱼缸的生长是缓慢的,靠自生方式来建构硝化系统的话,通常需要一个月或以上。一个硝化细菌中的亚硝酸菌繁殖周期大约是24—36小时,也就是说20小时后硝化细菌还停留在1个细菌的状态,而硝酸菌繁殖周期更长平均要花掉60个小时才能增值1倍,这也是造成新缸综合症的主要原因。所以对于这种情况,通常会自己加入一些硝化细菌,加速硝化系统的构建。 如果发现水质不良、换水、清洗过滤器、进行药物治疗以后,都可以不定期补充,以确保净水细菌的生态能成功的建立。
硝化菌在裸缸中所发挥的作用要比草缸大,因为大部分水草能代替硝化菌的作用。
硝化细菌使用注意事项:
1、不要和消毒杀菌药剂同时使用。
2、营造适合细菌生长的ph值。
3、营造适合细菌生长的温度。
4、不要和其他不共生的细菌共养。
5、提供好硝化细菌生存的温床。
鱼友还有什么不懂的问题欢迎在下方留言,我们帮你解决,敬请关注我们,下期见。
